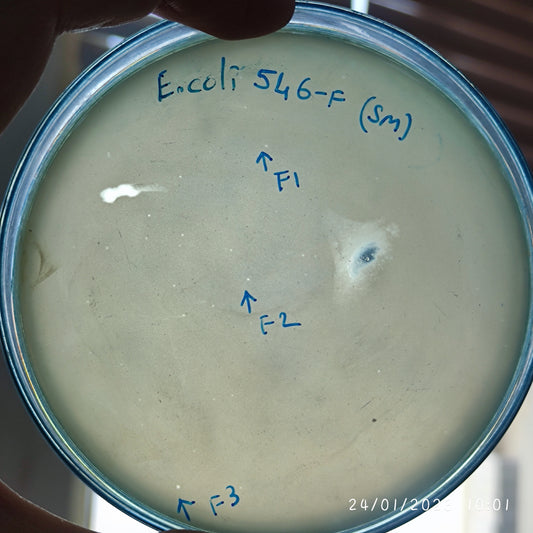
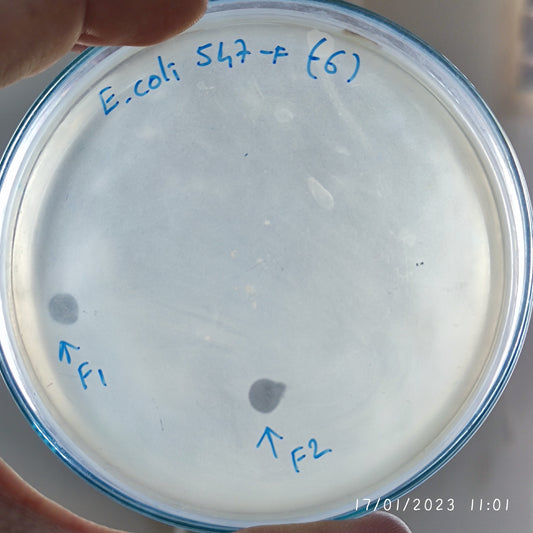
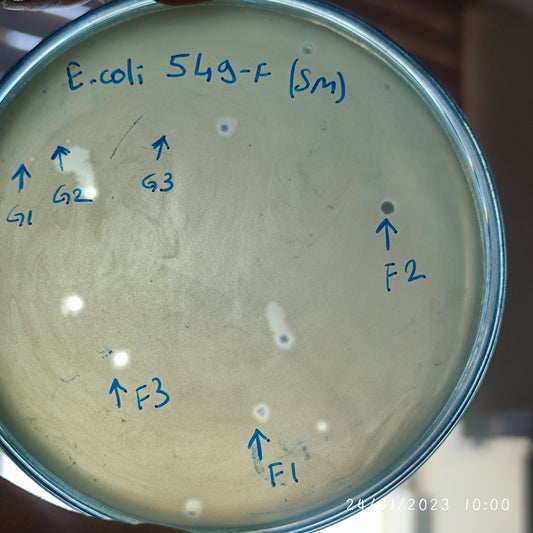
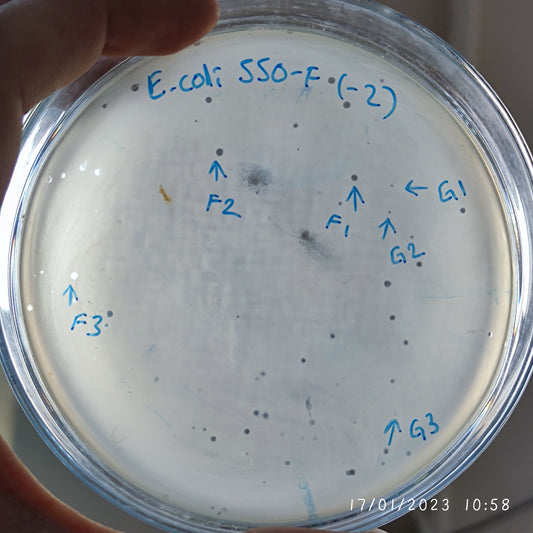
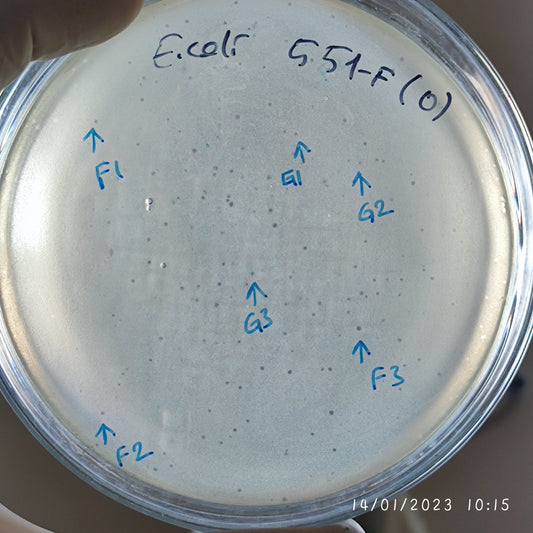
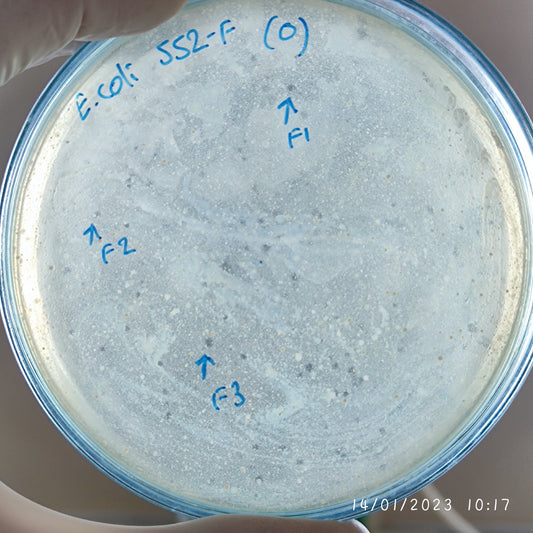
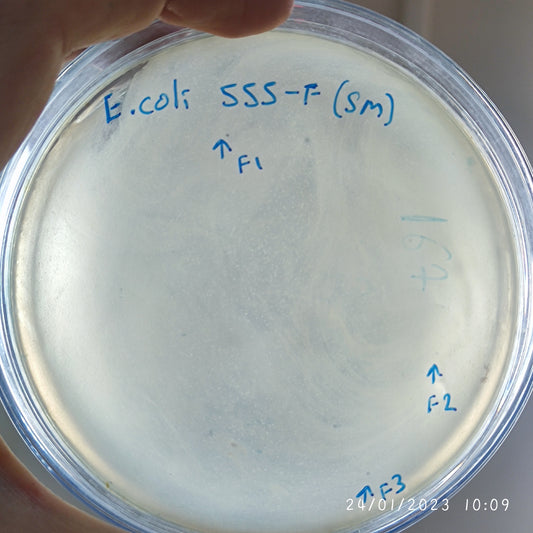
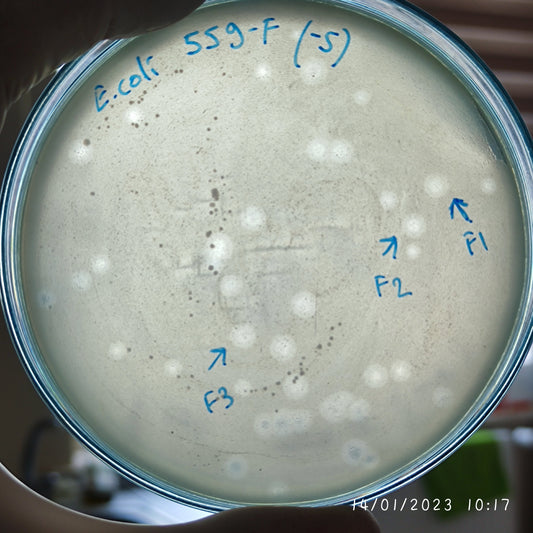
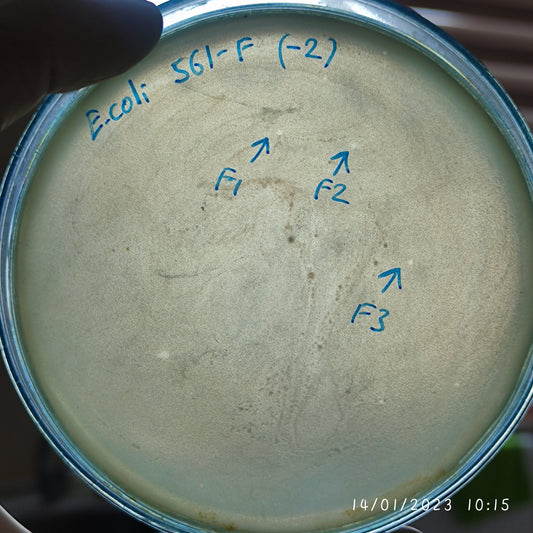
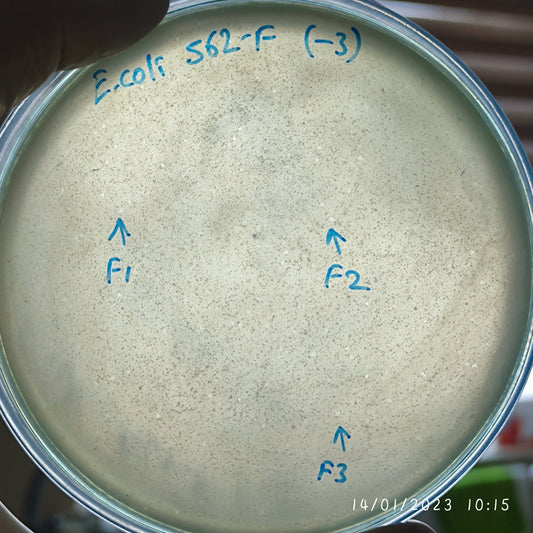
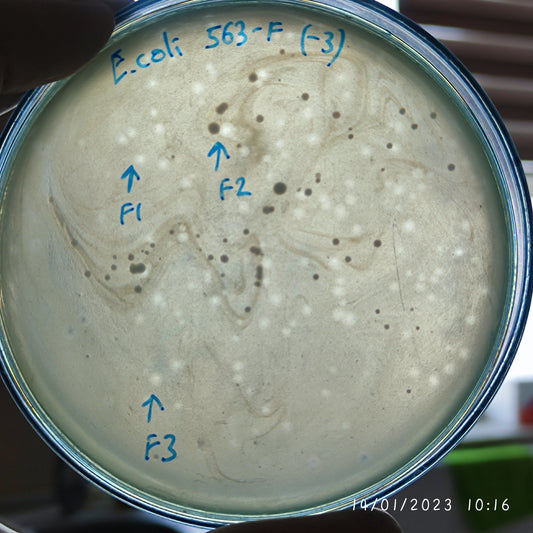
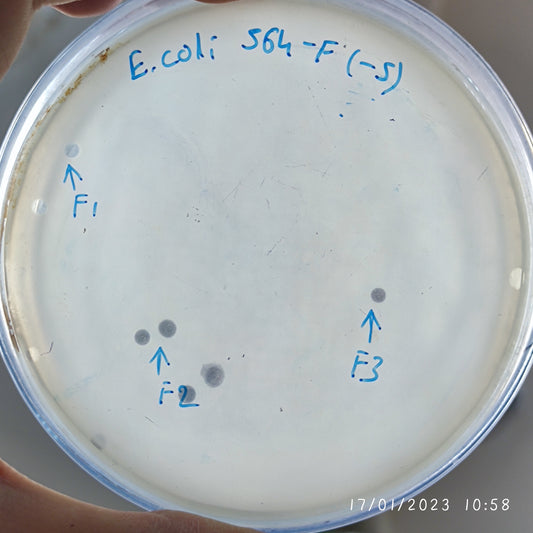

-
Escherichia coli bacteriophage 100546F
Regular price $800.00 USDRegular priceUnit price per -
Escherichia coli bacteriophage 100547F
Regular price $670.00 USDRegular priceUnit price per -
Escherichia coli bacteriophage 100548F
Regular price $500.00 USDRegular priceUnit price per -
Escherichia coli bacteriophage 100549F
Regular price $750.00 USDRegular priceUnit price per -
Escherichia coli bacteriophage 100549G
Regular price $750.00 USDRegular priceUnit price per -
Escherichia coli bacteriophage 100550F
Regular price $500.00 USDRegular priceUnit price per -
Escherichia coli bacteriophage 100550G
Regular price $500.00 USDRegular priceUnit price per -
Escherichia coli bacteriophage 100551F
Regular price $500.00 USDRegular priceUnit price per -
Escherichia coli bacteriophage 100551G
Regular price $500.00 USDRegular priceUnit price per -
Escherichia coli bacteriophage 100552F
Regular price $500.00 USDRegular priceUnit price per -
Escherichia coli bacteriophage 100555F
Regular price $750.00 USDRegular priceUnit price per -
Escherichia coli bacteriophage 100559F
Regular price $500.00 USDRegular priceUnit price per -
Escherichia coli bacteriophage 100561F
Regular price $400.00 USDRegular priceUnit price per -
Escherichia coli bacteriophage 100562F
Regular price $500.00 USDRegular priceUnit price per -
Escherichia coli bacteriophage 100563F
Regular price $500.00 USDRegular priceUnit price per -
Escherichia coli bacteriophage 100564F
Regular price $700.00 USDRegular priceUnit price per